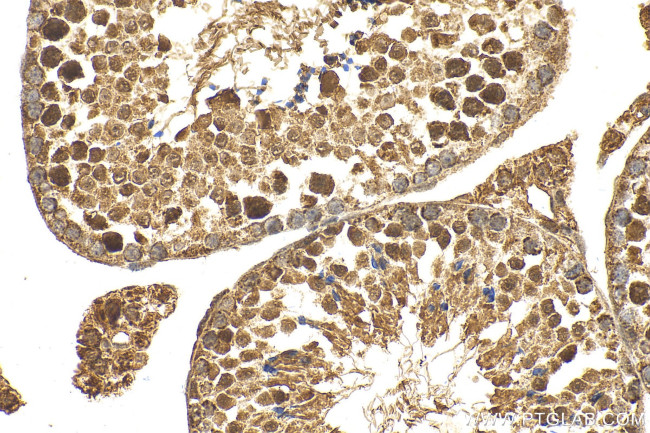
IQUB Antibody in Immunohistochemistry (Paraffin) (IHC (P))

Search
Proteintech
IQUB Polyclonal Antibody
{{$productOrderCtrl.translations['antibody.pdp.commerceCard.promotion.promotions']}}
{{$productOrderCtrl.translations['antibody.pdp.commerceCard.promotion.viewpromo']}}
{{$productOrderCtrl.translations['antibody.pdp.commerceCard.promotion.promocode']}}: {{promo.promoCode}} {{promo.promoTitle}} {{promo.promoDescription}}. {{$productOrderCtrl.translations['antibody.pdp.commerceCard.promotion.learnmore']}}
产品信息
25605-1-AP
种属反应
宿主/亚型
分类
类型
抗原
偶联物
形式
浓度
规格
纯化类型
保存液
内含物
保存条件
运输条件
产品详细信息
Immunogen sequence: MSNQQEKYEA QNIVNSTEES DDAFDTVTIP VPSEEPQESD QTEEHESGIE QFSESHAIHV EEQSDQSFSS LEPDNEQLME EVISPRQVSY TPQHHEKQYA MQRPNDDSLA FLDKIKSVKE SLQESVEDSL ATVKVVLIPV GQEIVIPFKV DTILKYLKDH FSHLLGIPHS VLQIRYSGKI LKNNETLVQH GVKPQEIVQV EIFSTNPDLY PVRRIDGLTD VSQIITVTVQ TGLDQYQQVP VEIVKSDFHK PFLGGFRHKV TGVEYHNAGT QTVPKRIPER LSIFCRDTQT VFQKKNLQQT TNTTSTQMTN IGVYVSNMTD KLVTPGKYFS AAEYHAQRLK AVIVIQTYYR
靶标信息
IQUB is a protein coding gene. May play roles in cilia formation and/or maintenance.
仅用于科研。不用于诊断过程。未经明确授权不得转售。
篇参考文献 (0)
生物信息学
蛋白别名: FLJ35834; IQ and ubiquitin-like domain-containing protein; IQ motif and ubiquitin-like domain-containing protein; unnamed protein product
基因别名: 4932408B21Rik; IQUB; TRS4
UniProt ID: (Human) Q8NA54, (Mouse) Q8CDK3
Entrez Gene ID: (Human) 154865, (Mouse) 214704